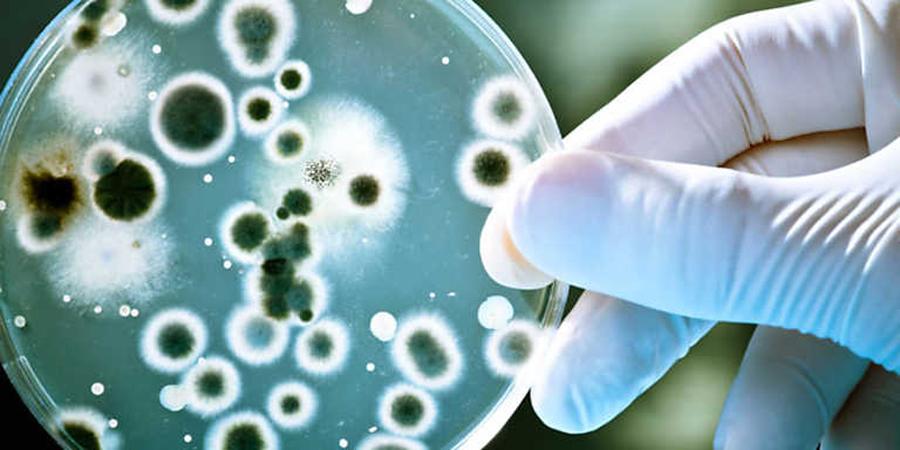
“الصحة العالمية” تنشر قائمة بأخطر أنواع البكتريا التي تقاوم “المضادات”

يلجأ الإنسان غالبًا إلى المضادات الحيوية للتخلص من البكتيريا والفيروسات التي قد تصيبه في مختلف أجزاء الجسم، وذلك بعد مراجعة الطبيب الذي يحدد النوع المناسب والقاتل لهذه البكتيريا، إلا أن هنا بكتيريا تفوقت على تلك الأدوية، ليبقى العالم في حاجة ماسة إلى أنواع جديدة من الدواء للقضاء عليها.
ونشرت منظمة الصحة العالمية، أمس الإثنين، القائمة الأولى من نوعها لأخطر أنواع البكتيريا، المقاومة للمضادات الحيوية، وذلك في مؤتمر صحفي بمقر المنظمة الدولية بنيويورك، عقده المتحدث الرسمي باسم الأمين العام للأمم المتحدة اسيتفان دوغريك.
وقال “دوغريك”: “منظمة الصحة العالمية نشرت القائمة الأولى من نوعها لمسببات الأمراض ذات الأولوية المقاومة للمضادات الحيوية، في فهرس من 12 عائلة من البكتيريا التي تشكل أكبر خطر على صحة الإنسان”.
وأوضح أن “الهدف من إعداد القائمة يتمثل في محاولة توجيه وتشجيع عمليات البحث والتطوير لمضادات حيوية جديدة، كجزء من جهود المنظمة للتصدي للمقاومة المتنامية عالميا للأدوية المضادة للجراثيم”.
وتنقسم قائمة منظمة الصحة العالمية إلى 3 فئات وفقًا لإلحاح الحاجة إلى مضادات حيوية جديدة: “ذات أولوية قصوى ومرتفعة ومتوسطة”.
وتضم المجموعة القصوى البكتيريا المقاومة للأدوية المتعددة التي تشكل تهديدا خاصا في المستشفيات ودور المسنين، وتشمل البكتيريا الراكدة والزائفة وعددًا من البكتريا المعوية، والتي يمكن لها أن تسبب التهابات شديدة ومميتة غالبًا مثل التهابات مجرى الدم والالتهاب الرئوي.
وتحتوي المجموعتان الثانية والثالثة على فئات البكتيريا الأخرى التي تتزايد مقاومتها للعقاقير وتسبب الأمراض الأكثر شيوعًا مثل السيلان والتسمم الناتج عن السالمونيلا.
وتسلط القائمة الضوء على تهديدات “البكتيريا سالبة الغرام” (وهي البكتيريا التي لا تحتفظ بصبغة الكريستال البنفسجي في بروتوكول صبغة الغرام)، التي تقاوم العديد من المضادات الحيوية ولديها القدرة على إيجاد طرق جديدة لمقاومة العلاج.
وبالإضافة إلى ذلك يمكن أن تورّث تلك البكتيريا خصائص تسمح لغيرها من البكتيريا بأن تصبح أيضًا مقاومة للعقاقير.
ولم يتم إدراج مرض السل، الذي تتزايد مقاومته للأدوية التقليدية مؤخرًا، كما لم يتم أيضًا إدراج عدد آخر من البكتيريا التي لديها مستويات منخفضة من المقاومة للأدوية الحالية ولا تشكل حاليًا خطرًا كبيرًا على الصحة العامة.
ووضعت القائمة بالتعاون مع شعبة الأمراض المعدية في جامعة توبنغن بألمانيا، باستخدام معايير متعددة التقنيات، من بينها مدى فتك العدوى التي تسببها البكتريا، وإذا كان علاجها يتطلب إقامة طويلة في المستشفى، وسهولة انتشارها بين الحيوانات ومن الحيوانات إلى البشر ومن شخص لآخر، وغيرها من المعايير.